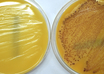

Potential superbug-killing compound
ScienceDaily | Mar 07, 2020
'Arms race' between bacteria and viruses
ScienceDaily | Feb 28, 2020
The new front against antibiotic resistance
Massachusetts Institute of Technology Research News | Jan 27, 2020
Why isn't there a vaccine for staph?
Newswise | Dec 26, 2019
FDA authorizes marketing of diagnostic test that uses novel technology to detect MRSA bacteria
Food and Drug Administration | Dec 07, 2019
Drug-resistant staph can spread easily in household environments: The Lancet
MedicalXpress Breaking News-and-Events | Dec 04, 2019
How bacteria 'act as one' to escape antibiotics
Healthline/Medical News Today | Nov 28, 2019
Potent antimicrobial found that shows promise in fighting staph infections
Newswise | Nov 27, 2019
The rise of superbugs: Facing the antibiotic resistance crisis
Healthline/Medical News Today | Nov 21, 2019
A new approach to tackle superbugs
ScienceDaily | Oct 20, 2019